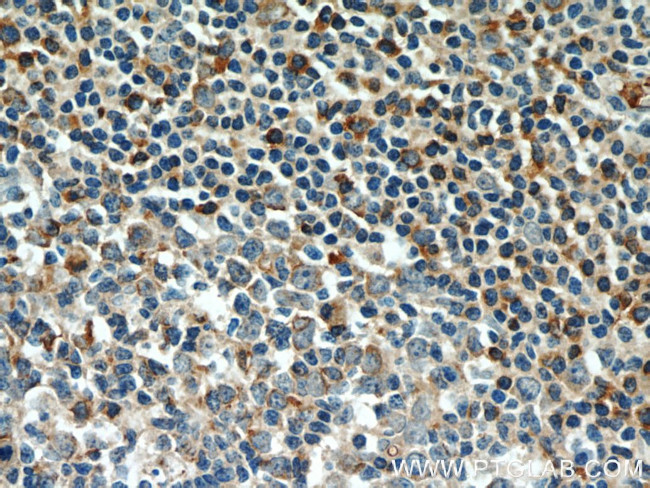
Integrin alpha-4 Antibody in Immunohistochemistry (Paraffin) (IHC (P))

Search
Proteintech
Integrin alpha-4 Polyclonal Antibody
{{$productOrderCtrl.translations['antibody.pdp.commerceCard.promotion.promotions']}}
{{$productOrderCtrl.translations['antibody.pdp.commerceCard.promotion.viewpromo']}}
{{$productOrderCtrl.translations['antibody.pdp.commerceCard.promotion.promocode']}}: {{promo.promoCode}} {{promo.promoTitle}} {{promo.promoDescription}}. {{$productOrderCtrl.translations['antibody.pdp.commerceCard.promotion.learnmore']}}
产品信息
19676-1-AP
种属反应
已发表种属
宿主/亚型
分类
类型
抗原
偶联物
形式
浓度
规格
纯化类型
保存液
内含物
保存条件
运输条件
靶标信息
The integrin alpha 4 (also known as CD49d and ITGA4) belongs to the integrin alpha chain family of proteins. Integrins are heterodimeric integral membrane proteins composed of an alpha and beta chains. Alpha4 chain associates with either beta1 or beta7 chain. It has been demonstrated that the putative ligand-binding sites of both integrin alpha4beta1 and alpha4beta7 is located on the alpha4 chain. These ligands included Madcam, VCAM, and fibronectin. Madcam is known as the principal ligand for integrin alpha4beta7. Recently it was also demonstrated that HIV-1 envelope can mimic Madcam by binding to and signaling though integrin alpha4beta7, the gut mucosal homing receptor for peripheral T cells.
仅用于科研。不用于诊断过程。未经明确授权不得转售。
生物信息学
蛋白别名: 269C wild type; alpha 4 subunit of VLA-4 receptor; antigen CD49D, alpha-4 subunit of VLA-4 receptor; CD49 antigen-like family member D; CD49d; Integrin alpha-4; Integrin alpha-IV; ITGA-IV; unnamed protein product; very late activation protein 4 receptor, alpha 4 subunit; VLA-4 subunit alpha
基因别名: CD49D; IA4; ITGA4
UniProt ID: (Human) P13612
Entrez Gene ID: (Human) 3676